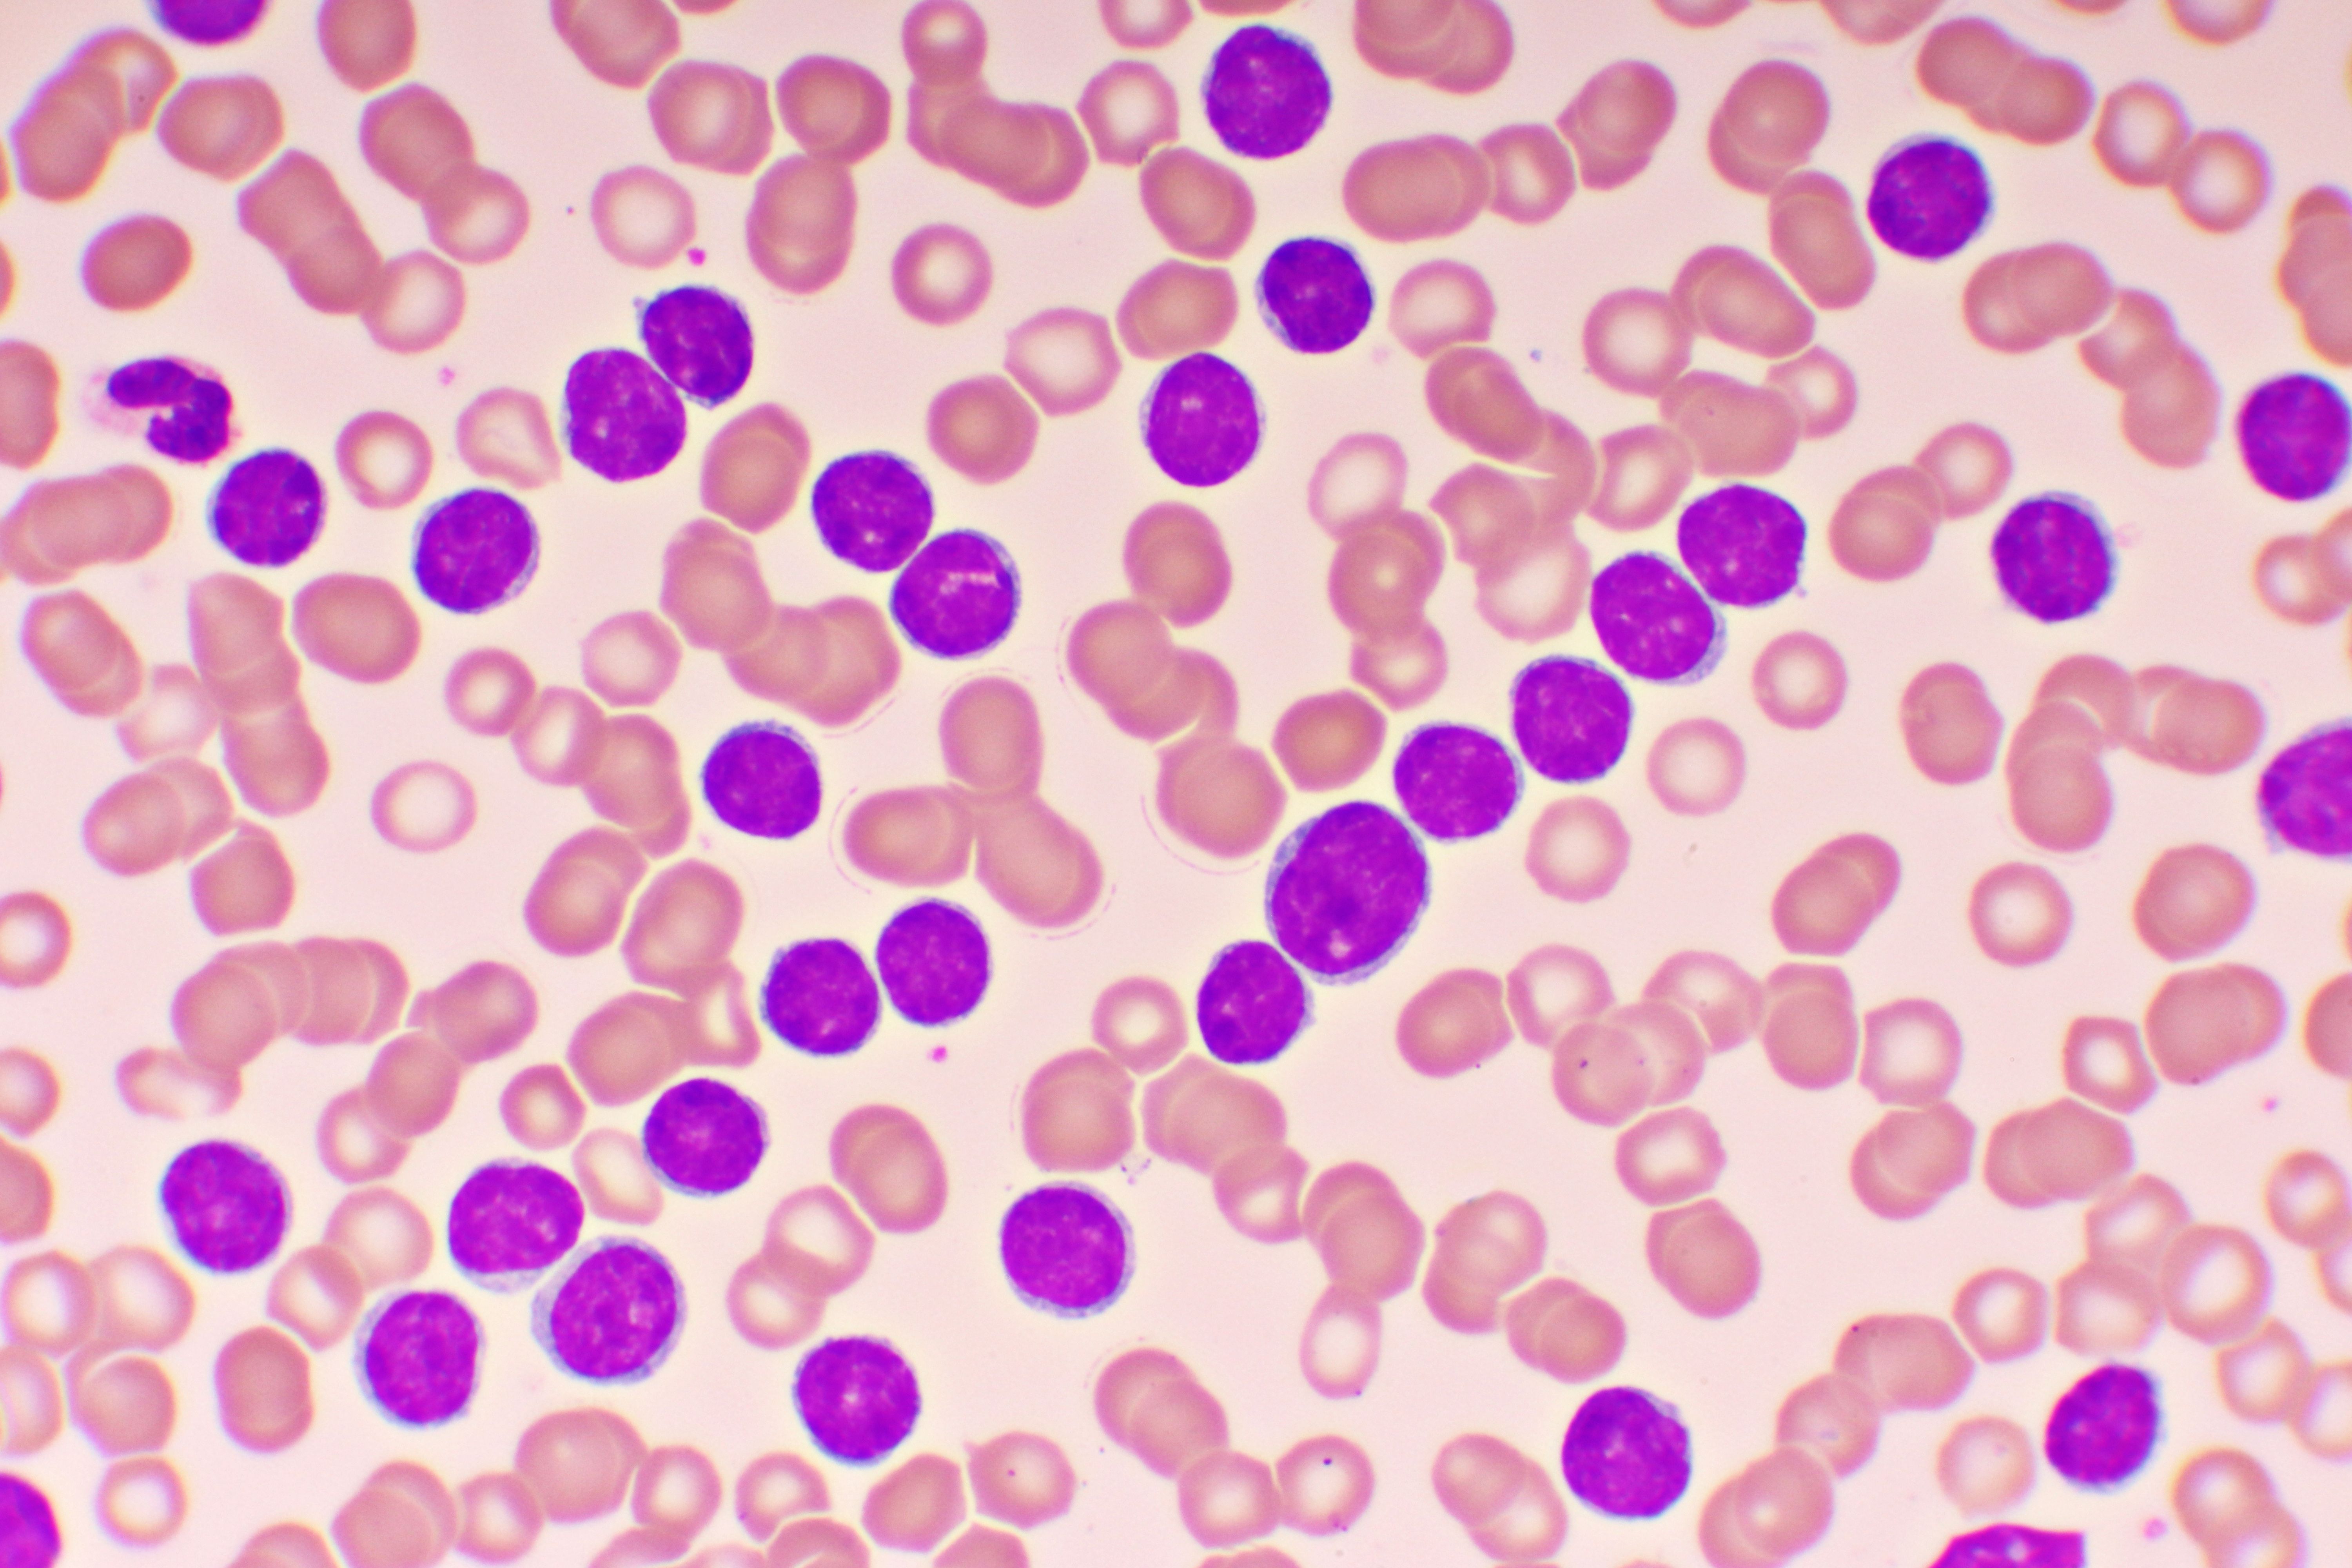

Кровь под микроскопом: лейкоз и здоровая кровь

Раздел: Сборник идей